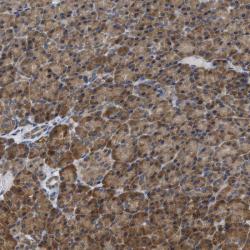

Antibody data
- Antibody Data
- Antigen structure
- References [1]
- Comments [0]
- Validations
- Immunohistochemistry [1]
Submit
Validation data
Reference
Comment
Report error
- Product number
- sc-48766 - Provider product page

- Provider
- Santa Cruz Biotechnology
- Proper citation
- Santa Cruz Biotechnology Cat#sc-48766, RRID:AB_2243544
- Product name
- Anti-BCAP31
- Antibody type
- Polyclonal
- Antigen
- Recombinant full-length protein
- Reactivity
- Human
- Host
- Rabbit
Submitted references Calcium-sensing receptors regulate cardiomyocyte Ca2+ signaling via the sarcoplasmic reticulum-mitochondrion interface during hypoxia/reoxygenation.
Lu FH, Tian Z, Zhang WH, Zhao YJ, Li HL, Ren H, Zheng HS, Liu C, Hu GX, Tian Y, Yang BF, Wang R, Xu CQ
Journal of biomedical science 2010 Jun 17;17(1):50
Journal of biomedical science 2010 Jun 17;17(1):50
No comments: Submit comment
Supportive validation
- Submitted by
- per
- Main image
- Experimental details
- Immunohistochemical staining of human pancreas shows cytoplasmic positivity in exocrine glandular cells.
- Validation comment
- Two independent antibodies targeting one protein yielding similar staining patterns. Staining pattern consistent with experimental and/or bioinformatic data.